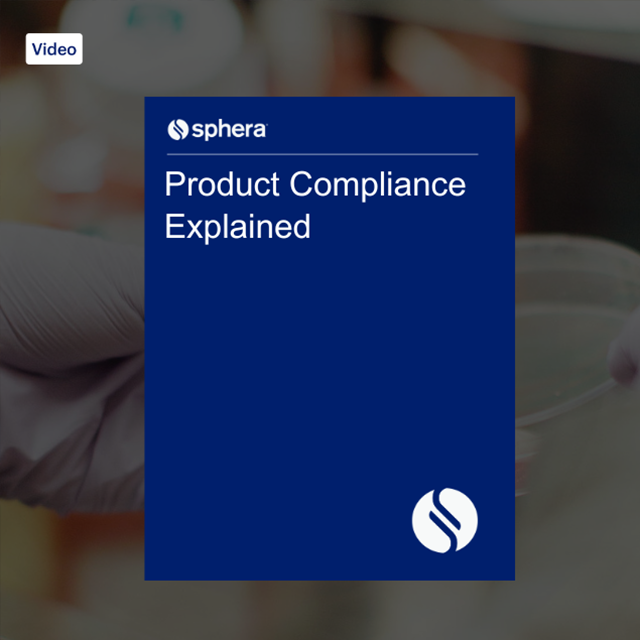
V Product Compliance Explained Thank You

Product Compliance Explained
The challenges product stewards and compliance leaders face are more complex than ever before. As they look to expand into new markets and launch new products, they need to manage compliance with constantly evolving regulations, disconnected and inefficient processes and limited resources. Meeting that goal requires the right expertise and the right product compliance services.